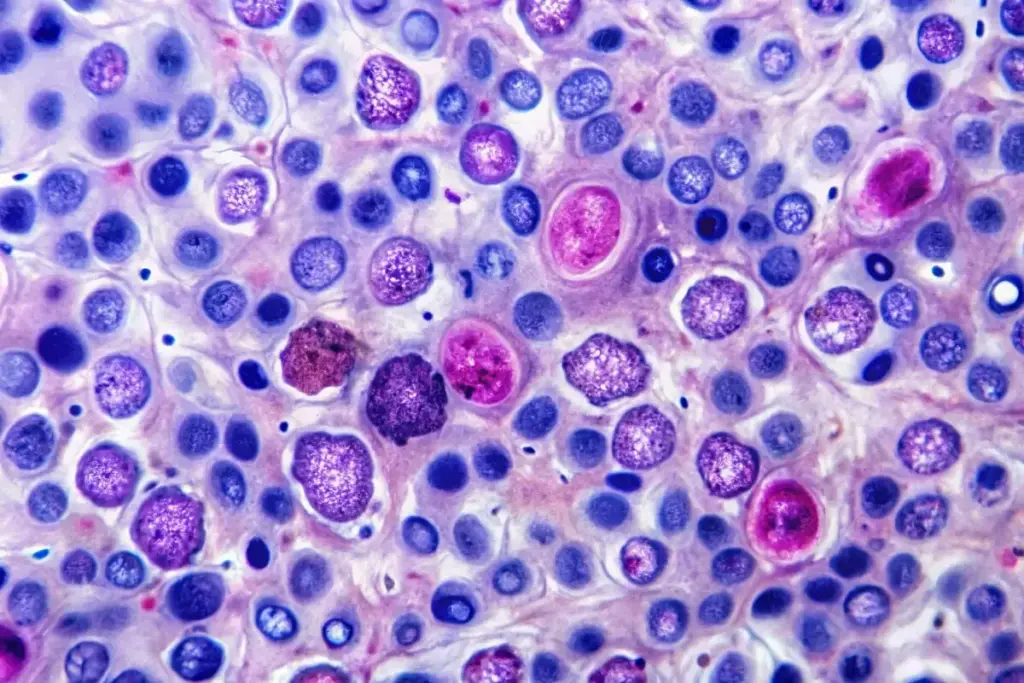
Myeloma And Stem Cell Transplant: The Best Facts 3 Myeloma And Stem Cell Transplant: The Best Facts

When treating multiple myeloma and blood cancers, two therapies are often considered: CAR T-cell therapy and stem cell transplant. They are both new and important, but they are used for different reasons.myeloma and stem cell transplant
CAR T-cell therapy modifies a patient’s T-cells to combat cancer. On the other hand, stem cell transplants help the body make blood again after strong chemotherapy.
At LIV Hospital, we offer treatments that are tailored to each patient. It’s important to know the difference between these therapies to choose the right treatment.
Key Takeaways
- CAR T-cell therapy and stem cell therapy are distinct treatments for blood cancers.
- CAR T-cell therapy targets and destroys cancer cells using genetically modified T-cells.
- Stem cell transplants restore blood-forming functions after high-dose chemotherapy.
- Personalized treatment approaches are key for effective care.
- LIV Hospital delivers innovative, protocol-driven treatments for blood cancers.
Understanding the Fundamentals of Cell-Based Therapies

Cellular therapies in cancer treatment have changed a lot. They now play a big role in how we fight this disease. It’s key to know how these therapies work, their history, and the various methods used.
The Role of Cells in Cancer Treatment
Cells are very important in cancer treatment, mainly with cellular therapies. CAR T-cell therapy and stem cell transplants are big examples. They help treat cancers like lymphoma and multiple myeloma by using the body’s own cells.
Evolution of Cellular Therapies in Oncology
Cellular therapy has made huge leaps forward, thanks to new insights into the immune system and cancer. have become more advanced. Now, they can target many types of cancer.
Distinguishing Different Cellular Approaches
CAR T-cell therapy and stem cell transplants are both cellular therapies but work differently. CAR T-cell therapy uses modified T cells to attack cancer. Stem cell transplants help the body make blood cells again after chemotherapy. Understanding these differences assists healthcare providers in selecting the most appropriate treatment for each patient.
What is CAR T-Cell Therapy?
CAR T-cell therapy is a new way to fight cancer. It changes a patient’s T-cells to find and kill cancer cells. This method has shown great promise in treating cancers like lymphoma and multiple myeloma.
The Science Behind CAR T-Cell Technology
Creating CAR T-cell therapy is a complex process. First, T-cells are taken from the patient’s blood or bone marrow. Then, these T-cells are changed to carry a special receptor that spots cancer cells.
After the change, the T-cells are put back into the patient. They then go after and destroy cancer cells. This technology helps the immune system fight cancer better.
How CAR T-Cells Target and Destroy Cancer
CAR T-cells work in several steps to fight cancer:
- Recognition: They are made to find specific proteins on cancer cells.
- Binding: The special receptor on the T-cell attaches to the protein on the cancer cell.
- Activation: This attachment makes the T-cell grow and become deadly to cancer cells.
- Cytotoxic Action: The T-cell then releases substances that kill the cancer cell.
This method helps CAR T-cells target cancer cells well. It also tries to avoid harming healthy cells.
The Manufacturing Process of CAR T-Cells
Creating CAR T-cells involves several important steps:
- T-cell Collection: T-cells are taken from the patient’s blood or bone marrow.
- Genetic Modification: The T-cells are then changed to carry the special receptor.
- Expansion: The modified T-cells are grown in number through cell culture.
- Cryopreservation: The final CAR T-cell product is frozen and ready for the patient.
Each step in making CAR T-cells is key to their success. By controlling these steps, doctors can make sure patients get the best treatment.
What is Stem Cell Therapy?
Stem cell therapy is a new way to treat diseases. It uses healthy stem cells to fix blood-making functions.
This therapy, also known as stem cell transplantation, replaces damaged stem cells with healthy ones. It’s key for those getting high-dose chemotherapy. This therapy aids the body in the regeneration of blood cells.
Types of Stem Cell Transplants: Autologous vs. Allogeneic
There are two main types of stem cell transplants: autologous and allogeneic.
- Autologous Stem Cell Transplant: This uses the patient’s own stem cells. They are collected, stored, and then given back after chemotherapy.
- Allogeneic Stem Cell Transplant: This uses stem cells from a donor. The donor can be a relative or someone else.
Each type has its benefits. The choice depends on the patient’s health, age, and condition.
The Process of Stem Cell Collection and Transplantation
The steps for collecting and transplanting stem cells are:
- Stem cell mobilization: The patient’s or donor’s stem cells are moved to the bloodstream.
- Stem cell collection: The stem cells are taken from the blood.
- Cryopreservation: The stem cells are frozen for later use.
- Conditioning regimen: The patient gets high-dose chemotherapy to get ready for the transplant.
- Stem cell infusion: The frozen stem cells are thawed and put into the patient’s blood.
How Stem Cells Restore Blood-Forming Functions
After infusion, the stem cells go to the bone marrow. There, they start making new blood cells.
This is very important for patients who have had high-dose chemotherapy. It helps their body recover and fight off infections.
Knowing about the different stem cell transplants helps patients choose the best treatment for them.
Key Differences Between CAR T-Cell and Stem Cell Therapies
CAR T-cell and stem cell therapies are new ways to fight cancer. They work in different ways and are used for different cancers. Both are types of cellular therapy, but they target and treat cancer differently.
Cellular Mechanisms and Targets
CAR T-cell therapy modifies a patient’s T-cells to combat cancer. These T-cells only attack cancer cells, not healthy ones. Stem cell therapy, on the other hand, gives healthy stem cells to help the bone marrow work right again.
CAR T-cell therapy is mainly for blood cancers. It’s very effective for some types. Stem cell therapy helps after high-dose chemotherapy by adding back blood cells.
Treatment Protocols and Administration
How these therapies are given is quite different. CAR T-cell therapy takes weeks to prepare and give back to the patient. Stem cell therapy involves collecting stem cells, then giving chemotherapy, and then the stem cells.
Patient Preparation and Recovery
Getting ready for these treatments is different too. CAR T-cell therapy might use a special treatment to make it work better. Stem cell therapy often uses strong chemotherapy to clear out the old bone marrow.
Recovering from these treatments is also different. CAR T-cell therapy can cause side effects like fever and brain problems. Stem cell therapy recovery waits for the new stem cells to start making blood cells. There’s a risk of problems like GVHD with donor stem cells.
Fundamental Purpose: Attack vs. Restore
CAR T-cell therapy aims to kill cancer cells using the immune system. Stem cell therapy’s main goal is to fix the blood-making system so it can make healthy blood cells again.
In summary, CAR T-cell and stem cell therapies are both important in cancer treatment. They have different goals and are used in different situations. Knowing these differences helps in making the right treatment choice.
Myeloma and Stem Cell Transplant: The Traditional Approach
Stem cell transplantation is a key treatment for multiple myeloma patients. Over time, it has become more effective, helping many patients.
Autologous Stem Cell Transplant for Multiple Myeloma
Autologous stem cell transplantation uses a patient’s own stem cells. These cells are collected, stored, and then given back after treatment. This method is safer for many patients because it lowers the risk of graft-versus-host disease (GVHD).
Benefits of Autologous Transplant:
- Lower risk of GVHD
- Faster engraftment
- Potential for improved response rates
Allogeneic Stem Cell Transplant Options
Allogeneic stem cell transplantation uses stem cells from a donor. It’s riskier, with a higher chance of GVHD. But, it might offer a cure by fighting myeloma.
Considerations for Allogeneic Transplant:
- Donor availability and matching
- Risk of GVHD and other complications
- Potential for long-term disease control
Success Rates and Long-term Outcomes
Success in stem cell transplantation for myeloma depends on several things. These include age, disease status, and overall health.
|
Treatment Type |
Overall Survival Rate |
Progression-Free Survival Rate |
|---|---|---|
|
Autologous Transplant |
80% |
50% |
|
Allogeneic Transplant |
60% |
40% |
Autologous stem cell transplantation usually leads to better survival rates. But, the right choice depends on the patient and their disease.
CAR T-Cell Therapy for Multiple Myeloma
CAR T-cell therapy is becoming a key part of treating multiple myeloma. Many clinical trials are underway to explore its benefits.
Emerging CAR T-Cell Treatments
CAR T-cell therapy starts by taking T-cells from a patient’s blood. These cells are then changed to find and attack cancer cells. In multiple myeloma, researchers are focusing on targets like BCMA.
BCMA-targeting CAR T-cells have shown great promise. They have high response rates in clinical trials.
Clinical Trial Results
Several trials have shown positive results for CAR T-cell therapy in multiple myeloma. For example, a study on BCMA-targeting CAR T-cells found an overall response rate of over 80%.
Patient Selection
Choosing the right patients for CAR T-cell therapy in multiple myeloma is important. Doctors look at several factors. These include the patient’s treatment history, disease status, and overall health.
- Previous treatment history
- Disease status
- Overall health condition
In conclusion, CAR T-cell therapy is a major step forward in treating multiple myeloma. It offers new hope to patients with this tough disease.
Stem Cell Transplant for Lymphoma: Applications and Outcomes
Stem cell transplant is a key treatment for lymphoma patients. It brings new hope in the fight against this complex disease. Lymphoma is a blood cancer with different types, like Hodgkin lymphoma (HL) and non-Hodgkin lymphoma(NHL). Each type needs a specific treatment plan.
Approaches for Hodgkin and Non-Hodgkin Lymphoma
The use of stem cell transplant differs for HL and NHL. This is because of the unique biology of each disease and the needs of patients. HL often uses autologous stem cell transplant for relapse or refractory cases. NHL treatment might be autologous or allogeneic, based on the disease subtype, patient age, and health.
Conditioning Regimens for Lymphoma Patients
Conditioning regimens are vital in stem cell transplant. They aim to clear the diseased bone marrow and prepare the patient. These regimens can be myeloablative or reduced-intensity, depending on the patient’s health and disease status.
|
Conditioning Regimen |
Description |
Patient Profile |
|---|---|---|
|
Myeloablative |
High-intensity chemotherapy and/or radiation |
Younger patients with fewer comorbidities |
|
Reduced-Intensity |
Lower-intensity chemotherapy and/or radiation |
Older patients or those with significant comorbidities |
Post-Transplant Maintenance Strategies
Post-transplant care is essential for disease control and managing complications. Maintenance strategies include watching for disease return, managing GVHD in allogeneic transplants, and supportive care to reduce treatment side effects.
Understanding stem cell transplant for lymphoma is key. It includes knowing the different treatments for HL and NHL, the conditioning regimens, and post-transplant care. This knowledge helps healthcare providers improve treatment outcomes and patient quality of life.
CAR T-Cell Therapy for Lymphoma: A Game-Changing Approach
CAR T-cell therapy is changing how we treat lymphoma. It brings new hope to patients. This treatment has shown great promise in clinical trials. It’s a strong option for those who haven’t responded well to other treatments.
Approved CAR T Products for Lymphoma
Several CAR T-cell products have been approved by the FDA for lymphoma. Axicabtagene ciloleucel (axi-cel) and tisagenlecleucel (tisa-cel) have shown they can treat certain types of non-Hodgkin lymphoma well.
This approval marks a significant advancement in lymphoma treatment. It gives patients a new, effective treatment. Clinical trials have shown these therapies can lead to high response rates. Some patients even experience complete remission.
Patient Journey Through CAR T Treatment
The journey with CAR T-cell therapy starts with leukapheresis. This is when a patient’s T-cells are collected. Then, these T-cells are sent to a lab to be engineered to fight cancer.
After the CAR T-cells are given back to the patient, they can cause side effects. These include cytokine release syndrome (CRS) and neurotoxicity. It’s important to manage these side effects well for the patient’s recovery.
Managing Unique Toxicities in Lymphoma Patients
It’s key to manage the special side effects of CAR T-cell therapy. CRS and neurotoxicity are the main ones. They need quick and effective treatment.
Doctors use tocilizumab for CRS and corticosteroids for neurotoxicity. Keeping a close eye on patients and providing supportive care is vital. This helps them deal with these side effects.
Comparative Efficacy: Clinical Trial Data
Studies show how CAR T-cell therapy and stem cell transplant compare. We’ll look at recent studies to see which is more effective.
Overall Response Rates: 80% CAR T vs. 73% Stem Cell Transplant
Clinical trials found CAR T-cell therapy works for about 80% of patients. Stem cell transplant works for about 73%. This shows CAR T-cell therapy might be better for some patients. The higher response rate with CAR T-cell therapy comes from its targeted attack on cancer cells.
Progression-Free Survival: 42% vs. 54% at Two Years
Progression-free survival (PFS) is key in judging treatment success. At two years, CAR T-cell therapy’s PFS is 42%, while stem cell transplant’s is 54%. This means CAR T-cell therapy might start working faster, but stem cell transplant could last longer for some. The right choice depends on the patient and their disease.
Quality of Life Considerations
Quality of life matters a lot in cancer treatment. It affects how well patients can recover and feel. Things like how treatments affect patients, how long they stay in the hospital, and long-term side effects matter too. Looking at these helps doctors choose the best treatment for each patient.
Side Effects and Complications
It’s important to know about the side effects and complications of CAR T-cell therapy and stem cell transplant. These treatments are new and help fight cancer, but they also have challenges. Patients and doctors need to work together to handle these issues.
Common Side Effects of Stem Cell Transplantation
Stem cell transplantation treats cancers like multiple myeloma and lymphoma. But, it can cause several side effects. These include:
- Infection risk due to immunosuppression
- Graft-versus-host disease (GVHD) in allogeneic transplants
- Mucositis and gastrointestinal issues
- Fatigue and anemia
Managing these side effects needs a detailed care plan. This includes using medicines, watching closely, and providing support.
CAR T-Cell Therapy Toxicities: CRS and Neurotoxicity
CAR T-cell therapy is promising for some cancers, but it has unique side effects. The main ones are cytokine release syndrome (CRS) and neurotoxicity.
Cytokine Release Syndrome (CRS) is a serious condition. It happens when CAR T-cells release a lot of cytokines. Symptoms can be mild (fever, fatigue) or severe (hypotension, organ dysfunction).
Neurotoxicity can cause confusion, memory loss, and even cerebral edema. It’s important to catch and treat these problems early.
Managing and Mitigating Treatment Complications
Handling complications from CAR T-cell therapy and stem cell transplant needs teamwork. This includes:
- Pre-treatment counseling and preparation
- Close monitoring during treatment
- Proactive management of side effects
- Supportive care measures to enhance recovery
Knowing about the side effects and complications helps us support patients better. This improves their treatment journey and quality of life.
Patient Selection: Who is Suitable for Each Therapy?
Finding the right patients for CAR T-cell therapy and stem cell transplant is key. It’s about looking at many things. This includes the patient’s health, how far the disease has spread, and other personal details.
Ideal Candidates for Stem Cell Transplantation
Stem cell transplant is best for some cancers, like multiple myeloma or lymphoma. The best candidates usually have:
- Good organ function to handle the transplant
- A disease that can be treated well
- Not too many health problems to lower risk of side effects
Age, overall health, and past treatments also play a big role in who can get a stem cell transplant.
When CAR T-Cell Therapy is Recommended
CAR T-cell therapy is suggested for those with cancer that has come back or didn’t get better with other treatments. Important things to consider are:
- Patients with certain cancers, like some leukemias or lymphomas
- Those who have tried all other treatments
- People who can handle the therapy well
CAR T-cell therapy is a hopeful choice for those with few other options.
Contraindications and Cautions
Both CAR T-cell therapy and stem cell transplant have risks and things to avoid. For example:
- Active infections or big organ problems might stop these treatments
- People with certain health histories need extra thought
- Checking the patient’s immune system is very important
It’s vital to think about these carefully. This ensures the chosen treatment is safe and works for the patient.
The Cost Factor: Financial Implications of Both Therapies
Both CAR T-cell therapy and stem cell transplant have big financial costs. These costs include not just the treatment itself but also indirect costs and long-term financial plans.
Insurance Coverage and Reimbursement Challenges
Insurance for CAR T-cell therapy and stem cell transplant varies a lot. Some plans cover a lot, but others leave patients with big bills.
- Pre-approval requirements: Many insurance companies need pre-approval, which can slow things down.
- Coverage limitations: Some policies don’t cover all treatment costs, like follow-up care or managing side effects.
- Reimbursement challenges: Getting reimbursed for treatment costs can be hard, and patients might need help from advocacy groups.
Long-term Economic Considerations
The costs of CAR T-cell therapy and stem cell transplant don’t stop after treatment. They also include follow-up care, managing side effects, and how they affect a patient’s work and income.
“The economic burden of cancer treatment is not limited to the cost of the treatment itself but also includes indirect costs such as lost productivity and the cost of caring for a patient.” –
A study on the economic burden of cancer treatment
Patient Assistance Programs
There are patient assistance programs for those getting CAR T-cell therapy and stem cell transplant. These programs help with treatment costs, travel, and where to stay.
- Manufacturer assistance programs: Some drug companies help with financial costs for their products.
- Non-profit organizations: Many non-profits give financial help and support to cancer patients.
- Government programs: Some government programs offer financial help to eligible patients.
Understanding the costs and looking for help can make it easier for patients to deal with the costs of CAR T-cell therapy and stem cell transplant.
Treatment Sequencing and Combinations
Using CAR T-cell therapy and stem cell transplant together needs careful thought. We must understand how to mix and order these treatments. This affects how well patients do.
First-Line vs. Relapsed/Refractory Settings
Choosing between CAR T-cell therapy and stem cell transplant depends on many things. These include the cancer type, the patient’s health, and past treatments. First-line treatment is the first treatment for a disease. CAR T-cell therapy might be used first for aggressive diseases or when initial treatments fail.
Stem cell transplant is often used when treatments have failed. But, new studies show it can also work in the first line for high-risk patients.
Combination Approaches and Novel Strategies
Scientists are looking into combining CAR T-cell therapy and stem cell transplant. One idea is to use CAR T-cell therapy first, then stem cell transplant to keep the disease under control. This could lead to better results for some blood cancers.
- CAR T-cell therapy followed by stem cell transplant
- Stem cell transplant followed by CAR T-cell therapy
- Combining CAR T-cell therapy with other immunotherapies
New ideas include gene-edited CAR T-cells and allogeneic CAR T-cells. These might be more effective and easier to get.
Future Treatment Algorithms
As we learn more, treatment plans for blood cancers will change. Future plans will consider many things, like the patient’s health and how the disease behaves.
Creating personalized treatment plans will become key. This means doctors will tailor treatments to each patient. They might use new tests and predictive biomarkers to make these plans.
Specialized Treatment Centers: The LIV Hospital Approach
At LIV Hospital, we’re changing the game in cell therapy with our specialized treatment centers. Our method is all about giving patients the best care for cell therapies. This way, we aim for the best results for our patients.
Protocol-Driven Care for Cell Therapies
We create our treatment plans based on the latest research and guidelines. This ensures our patients get the safest and most effective treatments out there.
- Personalized treatment planning
- Advanced cell processing and manufacturing
- State-of-the-art infrastructure
“The key to successful cell therapy lies in the precision of the treatment protocol and the expertise of the medical team.”
Multidisciplinary Team Approach
Our team includes experts from hematology, oncology, and immunology. This ensures a complete approach to patient care.
We work together to create treatment plans that fit each patient’s needs. This way, we make sure every patient gets the best care possible.
Quality Enhancement and Innovation in Cell Therapy
At LIV Hospital, we’re always looking to improve and innovate in cell therapy. We do this through research, training our staff, and using new technologies.
Our dedication to quality is shown in our accreditations and certifications. This ensures that our patients receive high-quality care.
We’re always pushing the boundaries of what’s possible. This helps us offer new treatments that make a real difference in our patients’ lives.
Conclusion: Complementary Roles in Modern Cancer Care
Cancer treatment is getting more complex, but CAR T-cell therapy and stem cell transplant are key. They work together to help patients with myeloma and lymphoma. These treatments offer new hope for those fighting cancer.
At LIV Hospital, we focus on personalized care for each patient. We understand how CAR T-cell therapy and stem cell transplant differ. This knowledge helps us create the best treatment plans for our patients.
Using these therapies together shows our commitment to improving cancer care. As we keep learning and improving, CAR T-cell therapy and stem cell transplant will be even more important. They will help us give better care and results to our patients.
FAQ
What is the difference between CAR T-cell therapy and stem cell therapy?
CAR T-cell therapy modifies a patient’s T-cells to combat cancer. Stem cell therapy replaces damaged stem cells with healthy ones.
How does CAR T-cell therapy work in treating myeloma?
It targets specific proteins on myeloma cells. This helps get rid of cancer cells and achieve remission.
What are the types of stem cell transplants available for myeloma patients?
There are autologous and allogeneic stem cell transplants. Autologous uses the patient’s own stem cells. Allogeneic uses donor stem cells.
What are the success rates of stem cell transplant for multiple myeloma?
Success rates depend on age, disease stage, and health. Autologous transplants often lead to remission and better survival rates.
How is CAR T-cell therapy manufactured, and what is the process?
It starts with collecting a patient’s T-cells. Then, these cells are genetically modified to recognize cancer cells. The modified cells are infused back into the patient.
What are the common side effects of CAR T-cell therapy and stem cell transplant?
Side effects include cytokine release syndrome (CRS), neurotoxicity, graft-versus-host disease (GVHD), and infections. Managing these side effects is key for patient care.
How do I know if I’m a suitable candidate for CAR T-cell therapy or stem cell transplant?
It depends on disease stage, health, and previous treatments. Talking to a healthcare professional is important to find the best treatment.
What are the financial implications of CAR T-cell therapy and stem cell transplant?
These therapies can be expensive. Insurance coverage varies. Patient assistance programs and financial counseling can help with costs.
Can CAR T-cell therapy and stem cell transplant be used in combination or sequentially?
Research is ongoing to see if combining or sequencing these therapies is beneficial. Treatment plans are evolving to improve patient outcomes.
What is the role of LIV Hospital in providing cell therapy treatments?
LIV Hospital focuses on delivering high-quality care. They use a team approach and aim for innovation in cell therapy.
What happens if CAR T-cell therapy fails in multiple myeloma patients?
If it fails, other treatments like stem cell transplant, chemotherapy, or targeted therapy may be considered. The next steps depend on the patient’s situation and disease.
Are there any patient assistance programs available for CAR T-cell therapy and stem cell transplant?
Yes, there are programs to help with the cost of these therapies. They offer financial support, counseling, and resources.
References:
National Center for Biotechnology Information. Evidence-Based Medical Insight. Retrieved from https://pubmed.ncbi.nlm.nih.gov/38331676/